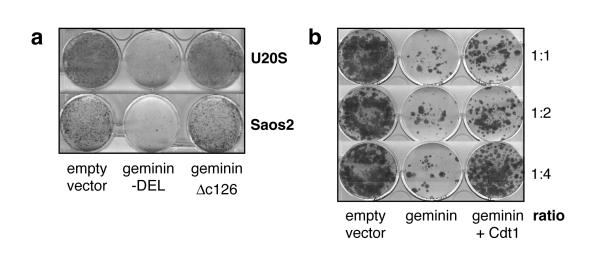

Abstract
Replication origins are “licensed” for a single initiation event by loading Mcm2-7 complexes during late mitosis and G1. Licensing is blocked at other cell cycle stages by the activity of cyclin-dependent kinases and a small protein called geminin. Here, we describe the effects of over-expressing a non-degradable form of geminin in various cell lines. Geminin expression reduced the quantity of Mcm2 bound to chromatin and blocked cell proliferation. U2OS (p53+/Rb+) cells showed an early S phase arrest with high cyclin E and undetectable cyclin A levels, consistent with the activation of an intra-S checkpoint. Saos2 (p53-/Rb-) cells showed an accumulation of cells in late S and G2/M with approximately normal levels of cyclin A, consistent with loss of this intra-S phase checkpoint. Geminin also induced apoptosis in both these cell lines. In contrast, IMR90 primary fibroblasts over-expressing geminin arrested in G1 with reduced cyclin E levels and no detectable apoptosis. A “licensing checkpoint” may therefore act in primary cells to prevent passage into S phase in the absence of sufficient origin licensing. These results suggest that inhibition of the licensing system may cause cancer-specific cell killing and therefore represent a novel anti-cancer target.
Keywords: replication licensing, geminin, Cdt1
Introduction
Cells ensure the precise duplication of chromosomal DNA in each cell cycle by dividing the replication process into two distinct stages. In the first stage, which occurs in late mitosis and early G1, replication origins are “licensed” for replication by being loaded with complexes of 6 minichromosome maintenance proteins, Mcm2-7 (Blow & Laskey, 1988; Diffley, 2001; Lei & Tye, 2001; Blow & Hodgson, 2002). These Mcm2-7 proteins form an important part of the pre-replicative complex (pre-RC) bound at replication origins in G1 of the cell cycle (Diffley et al., 1994; Labib et al., 2001). Following activation of CDK (cyclin-dependent kinase) and Cdc7 protein kinases at the onset of S phase, replication forks are initiated only at these licensed replication origins. As initiation occurs at each origin, the licence is removed. In order to prevent replicated origins from becoming re-licensed and hence re-replicated, the ability to load new Mcm2-7 complexes onto origins is prevented during late G1, S, G2 and early M. This inhibition is brought about by the combined activity of CDKs and an inhibitory protein called geminin (Diffley, 2001; Lei & Tye, 2001; Blow & Hodgson, 2002). Mcm2-7 play an essential part in DNA replication, probably providing the DNA helicase activity necessary to unwind the DNA ahead of the replication fork (Labib & Diffley, 2001).
At least three other proteins are required for origins to load Mcm2-7 and become licensed (Diffley, 2001; Lei & Tye, 2001; Blow & Hodgson, 2002). The Origin Recognition Complex (ORC) first binds to each replication origin, and then recruits two other proteins, Cdc6 and Cdt1. These act together to load Mcm2-7 complexes and functionally license the origin. The licensing of Xenopus sperm nuclei has recently been reconstituted with purified proteins (Gillespie et al., 2001). A crucial feature is that although ORC, Cdc6 and Cdt1 are all essential for Mcm2-7 loading, none of them are subsequently required to maintain the binding of Mcm2-7 to origins (Donovan et al., 1997; Hua & Newport, 1998; Rowles et al., 1999; Maiorano et al., 2000). An important consequence is that re-licensing of replicated DNA can be prevented by inhibition or removal of ORC, Cdc6 or Cdt1 once S phase has started, without displacing functional Mcm2-7 at licensed origins.
Evidence from a range of different organisms and cell types suggest that when cells withdraw from the cell cycle, either reversibly into G0 or irreversibly, they lose Mcm2-7 proteins and become functionally unlicensed (Tsuruga et al., 1997; Musahl et al., 1998; Stoeber et al., 2001; Sun et al., 2000; Tan et al., 2001). A similar reduction in Cdc6 protein is seen in G0 and permanently arrested cells (Stoeber et al., 1998). We have recently proposed that the presence or absence of licensed origins provides a functionally important distinction between cells in G1 and G0 (Blow & Hodgson, 2002). CDT1 has recently been shown to have oncogenic potential (Arentson et al., 2002), consistent with the idea that down-regulation of licensing in quiescent cells provides a check on their proliferative capacity.
Given this potential relationship, it is of interest to determine how human cells respond to inhibition of replication licensing - whether they respond by entering a G0-like state, or whether they proceed into S phase regardless. To specifically inhibit replication licensing, we used geminin, a specific inhibitor of Cdt1 (McGarry & Kirschner, 1998; Tada et al., 2001; Wohlschlegel et al., 2000). Overexpression of geminin in Drosophila leads to inhibition of DNA synthesis, increased numbers of metaphase cells and increased apoptosis (Quinn et al., 2001). This combination of features would be consistent with cells entering mitosis with unreplicated DNA and entering apoptosis as a consequence of being unable to correctly segregate the unreplicated chromosomes. Here, we show that different mammalian cells respond in different ways to geminin over-expression. U20S cells arrest in early S phase with downregulated cyclin A and undergo apoptosis. Saos2 cells in contrast continue to synthesise DNA and appear to try to continue through the cell cycle in the presence of geminin. Most dramatically, primary cells arrest with unreplicated DNA and low levels of cyclin E, as though capable of sensing that they have insufficient licensed origins to complete S phase. The differential response of cells to geminin over-expression suggests that the replication licensing system is a promising new target for anti-cancer drugs.
Results
To establish whether geminin could block proliferation of human tissue culture cells, we transfected U20S and Saos2 cells with an expression vector containing geminin-DEL, a non-degradable form of geminin resistant to cell cycle specific proteolysis (McGarry & Kirschner, 1998), and investigated the ability of transfected cells to form colonies after 3 weeks selection. As controls, cells were transfected with either empty vector or with vector containing a truncated version of geminin (geminin-ΔC126) incapable of inhibiting DNA replication. Geminin expression significantly abolished the colony forming ability of both cell lines compared to controls (Fig. 1a). To demonstrate that this effect of geminin was specific to inhibition of Cdt1, geminin was co-transfected with a Cdt1 expressing plasmid at increasing concentrations. Cdt1 efficiently rescued the inhibitory effect of geminin at a ratio of 1:4 (Fig.1b). In order to demonstrate that geminin expression inhibits DNA replication we microinjected geminin expression plasmids into HeLa cells followed by synchronisation in metaphase, and assessed BrdU incorporation 12 h after metaphase release. This caused a profound reduction in the number of BrdU-positive cells (data not shown). These results are all consistent with geminin inhibiting DNA replication in vivo by inhibition of Cdt1.
Figure 1.
Inhibition of cell proliferation by geminin and rescue by Cdt1.
a, U2OS cells were transfected with empty pcDNA3 vector, pcDNA3 containing a stable form of geminin (geminin-DEL) or pcDNA3 containing an inactive form of geminin (gemininΔc126). Cells were grown under selection for 3 weeks and colonies were then stained with Giemsa. b, U2OS cells were transfected with empty pcDNA3, or pcDNA3 expressing geminin-DEL plus or minus pcDNA3 expressing Cdt1 at a ratio of 1:1, 1:2 or 1:4. Cells were grown under selection for 3 weeks and then stained with Giemsa.
To facilitate the overexpression of geminin in a variety of different cell lines, we constructed an adenoviral delivery vector containing the geminin-DEL gene (Ad5GFP-geminin). As a control, the Ad5GFP vector lacking geminin was used. To estimate the efficiency of infection, cell lines were infected with Ad5GFP using a multiplicity-of-infection (MOI) of 100, and the proportion of GFP-expressing cells was counted. Four established cell lines (U20S, Saos2, BT549 and H1299) showed an infection efficiency of >95%, whilst IMR90, a primary cell line, showed an infection efficiency of >80%. No significant cytotoxic effect was noted at this viral concentration. Infection of these three cell lines with Ad5GFP-geminin resulted in substantial geminin expression (Fig. 2a). Previous work has shown that geminin inhibits DNA replication by inhibiting Cdt1 and thus preventing the loading of Mcm2-7 onto chromatin (McGarry & Kirschner, 1998; Tada et al., 2001; Wohlschlegel et al., 2000). We therefore infected U20S, Saos2 and IMR90 cells with either Ad5GFP or Ad5GFP-geminin and monitored the presence of Mcm2 on chromatin. Fig 2b shows that as expected, Ad5GFP-geminin infection caused a marked reduction of chromatin-bound Mcm2.
Figure 2.
Expression of geminin by adenovirus vector.
a, U2OS, Saos2 and IMR-90 cells were treated by mock infection or infection with Ad5GFP-geminin. Geminin expression was assessed by immunoblotting cell extracts 72 h and 96 h later. Blots were also probed with actin antibodies as a loading control. b, U2OS, Saos2 and IMR90 cells were infected with either Ad5GFP or Ad5GFP-geminin. After 72 h, total cell extracts were prepared (T) and fractionated into a soluble supernatants (S) or chromatin-containing pellets (P), and then immunoblotted for Mcm2.
Effect of geminin on U20S cells
We next used the adenoviral expression system to characterise in detail the effect of geminin overexpression in U2OS cells, an osteosarcoma-derived cell line that expresses both Rb and p53. Ad5GFP-geminin caused a cessation of cell proliferation and a reduction in cell number 72-96 h after infection (Fig 3a). Flow cytometry showed that geminin expression caused an accumulation of cells with a DNA content between G1 and G2 levels, consistent with cells being unable to complete S phase (Fig 3b). In addition, the geminin-expressing cells showed a marked sub-G1 population, consistent with the induction of apoptosis. A similar cell cycle profile in geminin-expressing U20S cells has recently been reported (Wohlschlegel et al., 2002). In contrast, Ad5GFP infected cells demonstrated no significant abnormalities in cell cycle profile. To confirm that the geminin-expressing cells were arresting in S phase, cells were infected with Ad5GFP and Ad5GFP-geminin, and 96 h later were either immunostained with anti-PCNA antibodies, or pulsed with BrdU and immunostained with anti-BrdU antibodies. The majority of the geminin-expressing cells stained strongly for PCNA, as expected if they were arrested in S phase (Fig 4a). Further, the geminin-expressing cells incorporated only low levels of BrdU into DNA at this time (Fig 4b).
Figure 3.
Analysis of adenovirus-infected U2OS.
U2OS cells were infected with either Ad5GFP or Ad5GFP-geminin or were mock-infected. a, At different times, cell number was measured and expressed as the percentage change over mock-infected controls at time 0 h. Numbers represent the mean of three independent experiments. b, 72 h (top panel) or 96 h (bottom panel) after infection cellular DNA was stained with propidium iodide and analysed by flow cytometry.
Figure 4.
PCNA and BrdU staining of adenovirus-infected U2OS.
U2OS cells were infected with either Ad5GFP or Ad5GFP-geminin and were incubated for 96 h. a, Cells were fixed and PCNA was detected by indirect immunofluorescence with an anti-PCNA antibody and fluorescein-labelled secondary antibody. DNA was stained with DAPI. b, Cells were pulsed for 30 min with BrdU, fixed and detected with an anti-BrdU antibody and Texas red labelled secondary antibody. DNA was stained with DAPI.
Cell lysates were immunoblotted for cyclin A and E (Fig 5a). This showed that the geminin-expressing cells contained high levels of cyclin E, consistent with an S phase arrest. In contrast, cyclin A levels were low. Although cyclin A is normally expressed during S phase, its levels are down-regulated in response to genotoxic stress (Knudsen et al., 1998; Guo et al., 2000; Knudsen et al., 2000; Sever-Chroneos et al., 2001), so this may indicate that the geminin-expressing cells had activated a cell stress checkpoint. Consistent with this interpretation, the geminin-expressing cells contained high levels of p53 and Cip1/Waf1 (Fig 5a) and showed a profound loss of phosphorylated Rb (data not shown). Significantly, p53 became phosphorylated on serine 15, indicating activation of the ATM/ATR checkpoint pathways (Abraham, 2001).
Figure 5.
Cell cycle status of adenovirus-infected U2OS.
U2OS cells were infected with either Ad5GFP or Ad5GFP-geminin or were mock-infected. a, At 72 or 96 h (72 h for mock-infected cells) cell extracts were prepared and stained with antibodies against cyclin E, cyclin A, p53, p53 phospho-serine 15, Cip1/Waf1 or actin. b, An in situ TUNEL assay was performed 96 h post infection. Total DNA was stained with DAPI.
The flow cytometry profile (Fig 3b) showed a significant number of cells with a sub-G1 DNA content indicative of cells undergoing apoptosis. We took several approaches to verify that geminin-induced cell death was the result of apoptosis. First, cell morphology demonstrated typical changes characteristic of apoptotic cell death, including cell shrinkage, cytoplasmic blebbing, chromatin condensation, nuclear fragmentation and formation of apoptotic bodies (data not shown). These changes were not seen in mock-infected or Ad5CMV-GFP infected cells. Apoptosis is associated with inter-nucleosomal degradation of genomic DNA, which can be assessed by in situ TUNEL staining. At 96 hr after infection, Ad5GFP-geminin infected cells demonstrated abundant TUNEL staining compared to controls (Fig. 5b). In addition, we detected the typical apoptotic cleavage product of poly ADP ribose polymerase (PARP) in the geminin-expressing cells (data not shown).
To investigate the relationship between S phase arrest and apoptosis, we varied the MOI of the Ad5GFP-geminin from 1 to 100, and then analysed the cellular DNA content by flow cytometry. The results (Fig 6) showed that even at an MOI of 1, there was an increase in the number of early S phase cells as well as the appearance of apoptotic cells. As the MOI was increased, the proportion of cells in early S phase also increased, coupled with an increase in apoptotic cells. Taken together, these results suggest that as a consequence of forced geminin expression, U2OS cells enter S phase but experience problems in completing DNA replication which leads to the activation of the checkpoint machinery. This causes down-regulation of cyclin A and induction of Cip1/Waf1, which in turn blocks further S phase progression and eventually triggers apoptosis.
Figure 6.
Cell cycle analysis in U2OS cells infected with increasing MOI of Ad5GFP-geminin.
U2OS cells were infected with either Ad5GFP or Ad5GFP-geminin or were mock-infected, at the indicated MOI. 96 h after infection cellular DNA was stained with propidium iodide and analysed by flow cytometry.
Effect of geminin overexpression in other cell lines
We next investigated whether the response of U2OS cells to geminin over-expression is typical of other cell lines, or whether significant differences exist. H1299 cells, a lung cancer-derived cell line, responded to Ad5GFP-geminin infection in a similar way to U2OS (data not shown). H1299 cells arrested with a G1/S DNA content and high Cip1/Waf1 levels, with a significant proportion of apoptotic cells being present. Since H1299 are p53 null, this suggests that p53 is not necessary for the early S phase arrest or induction of apoptosis following geminin over-expression.
However, when Ad5GFP-geminin infections were repeated with Saos2 cells, somewhat different results were obtained. U2OS and Saos2 are both osteosarcoma-derived cell lines, but unlike U2OS, Saos2 contains neither p53 nor Rb. Ad5GFP-geminin infection caused a decline in Saos2 cell numbers (Fig 7a), though this was somewhat slower than was seen in U2OS cells (Fig 3a). Flow cytometry of Ad5GFP-geminin infected Saos2 cells showed a marked increase in cells in late S and G2/M (Fig 7b) instead of an accumulation of early S phase cells as was seen with U2OS. A lack of clear S phase arrest was demonstrated by BrdU staining, which revealed significant DNA synthesis occuring in many cells (Fig 7c). Consistent with this, the geminin-expressing Saos2 cells had low but detectable levels of cyclin A (Fig 7d). However a significant proportion of the Ad5GFP-geminin infected Saos2 cells had a sub-G1 DNA content (Fig 7b). TUNEL staining confirmed that these were apoptotic cells (data not shown). At 144 hr post-infection, the majority of the Saos2 cells were apoptotic (data not shown). Similar results were obtained with BT549 breast cancer-derived cells that are also p53 and Rb null (data not shown). This suggests that Saos2 and BT549 cells have lost the ability to down-regulate cyclin A and cannot undergo the early S phase arrest seen in U2OS and H1299 cells, but eventually undergo apoptosis.
Figure 7.
Analysis of adenovirus-infected Saos2.
Saos2 cells were infected with either Ad5GFP or Ad5GFP-geminin or were mock-infected. a, At different times, cell number was measured and expressed as the percentage change over mock-infected controls at time 0 h. Numbers represent the mean of three independent experiments. b, 96 h after infection cellular DNA was stained with propidium iodide and analysed by flow cytometry. c, At 96 h, infected cells were pulsed for 30 min with BrdU, fixed and detected with an anti-BrdU antibody and Texas red labelled secondary antibody. DNA was stained with DAPI. d, At 72 or 96 h cell extracts were prepared and immunoblotted with antibodies against cyclin E, cyclin A or actin.
We next examined how IMR90 primary fibroblasts responded to geminin-overexpression. 48-72 hr after infection with Ad5GFP-geminin, IMR90 cells had ceased proliferation (Fig 8a). However, by 96 hr some proliferation resumed, possibly due to overgrowth by non-infected cells, which became more abundant at this time. Flow cytometry showed that by 72 hr geminin expression in primary cells led to an accumulation of cells with a G1 DNA content, with few cells in S phase, and no sign of apoptosis (Fig 8b). The Ad5GFP-geminin infected cells contained low levels of both cyclin E and A, consistent with them arresting prior to entry into S phase (Fig 8c). Further, virtually no immunostaining with anti-PCNA antibodies was seen in the geminin-expressing primary cells showing that they had not initiated DNA synthesis (Fig 8c). The geminin-expressing cells showed a slight induction of p53, a more significant induction of Cip1/Waf1 (Fig 8d) and a profound loss of phosphorylated Rb (data not shown), which may contribute to the cell cycle arrest. Significantly, the level of p53 phosphorylation at serine 15 remained at background levels (Fig 8d), suggesting that the ATM/ATR checkpoint pathways were not activated. The G1/G0 arrest of IMR90 cells in response to geminin expression is therefore quite distinct from the response of the cancer-derived cell lines.
Figure 8.
Analysis of Ad5GFP-geminin infected primary fibroblasts.
IMR90 cells were infected with either Ad5GFP or Ad5GFP-geminin or were mock-infected. a, At different times, cell number was measured and expressed as the percentage change over mock-infected controls at time 0 h. Numbers represent the mean of three independent experiments. b, 72 h after infection cellular DNA was stained with propidium iodide and analysed by flow cytometry. c, At 72 h cells were fixed and PCNA was detected by indirect immunofluorescence with an anti-PCNA antibody and fluorescein-labelled secondary antibody. DNA was stained with DAPI. d, At 72 h cell extracts were prepared and stained with antibodies against cyclin E, cyclin A, p53, p53 phospho-serine 15, Cip1/Waf1 or actin. Note that the p53 phospho-serine 15 blot was produced in parallel with the one in Fig 5a and is shown at the same exposure.
Discussion
We have used geminin to inhibit replication licensing in a variety of different cell types. This has revealed that different cell types respond to geminin over-expression in at least 3 different ways. Analysis of these results suggests that compounds mimicking the action of geminin could make highly specific anti-cancer agents.
Requirement for Cdt1 and Mcm2-7 in human cell proliferation
Work in model organisms has shown that Mcm2-7 play an essential role in DNA replication, possibly by providing the helicase activity that opens up single-stranded DNA ahead of the replication fork (Labib & Diffley, 2001). The loading of Mcm2-7 onto origin DNA, which results in the origin being “licensed” for replication, also depends on ORC, Cdc6 and Cdt1 proteins (Diffley, 2001; Gillespie et al., 2001; Lei & Tye, 2001; Blow & Hodgson, 2002). We have used geminin, a specific inhibitor of Cdt1 (McGarry & Kirschner, 1998; Tada et al., 2001; Wohlschlegel et al., 2000), to inhibit Mcm2-7 loading and origin licensing in human cells. Since geminin is normally unstable during late mitosis and early G1 (McGarry & Kirschner, 1998), we used a non-degradable mutant of geminin to stably inhibit Cdt1 throughout the cell cycle. However, it is possible that even this stabilised form of geminin can be inactivated by other means (Hodgson et al., 2002). Introduction of non-degradable geminin into human cells, by transfection, microinjection or infection inhibited both the loading of Mcm2 onto chromatin and overall cell proliferation. The inhibition of cell proliferation was reversed by overexpression of Cdt1 and was not seen with a deletion mutant incapable of inhibiting Cdt1, suggesting that inhibition was mediated by inhibition of origin licensing.
Expression of stabilised geminin significantly reduced the quantity of chromatin-bound Mcm2. Previous work in yeast (Lei et al., 1996), humans (Burkhart et al., 1995) and Xenopus (Mahbubani et al., 1997) has estimated that >10 copies of the Mcm2-7 complex can be loaded onto each replication origin. Experiments in Xenopus showed that when the levels of Mcm2-7 were lowered to ~1 copy per origin, overall replication rates were still maximal; only when Mcm2-7 was present at less than these levels was the bulk DNA replication rate lowered (Mahbubani et al., 1997). The ability of geminin-expressing Saos2 and BT549 to support significant levels of DNA synthesis is consistent with this previous work. Saos2 and BT549 showed a marked accumulation in late S and G2 phases of the cell cycle, as though they were unable to complete DNA replication. One plausible explanation for this effect is that although most replication origins had initiated, some had not. Replication origins in yeast have been shown to be differentially sensitive to reduced Mcm2-7 levels (Maine et al., 1984). For example, halving the dosage of Mcm2 can dramatically decrease the replication from a specific set of replication origins (Lei et al., 1996). Therefore in response to lowered Mcm2-7, bulk DNA synthesis in Saos2 and BT549 may occur at almost normal rates whilst certain chromosomal origins are inactivated. This could prevent the cell from completing DNA replication and therefore lead to arrest in late S and apoptosis. Alternatively, apoptosis could be triggered as a consequence of the cells trying to undergo mitosis in the presence of unreplicated DNA, as occurs when geminin is over-expressed in Drosophila (Quinn et al., 2001).
Unlike Saos2 and BT549 cells, most U2OS and H1299 cells infected with AdGFP-geminin arrested in early S phase with less than half of their DNA replicated. Although PCNA was present in foci, only low levels of BrdU incorporation were seen, suggesting that replication forks had been initiated as cells entered S phase, but replication had then been shut down. This shut-down of replication in geminin-expressing U2OS cells could plausibly be due to activation of an intra-S phase checkpoint. In yeast, DNA damage or stalling of replication forks in early S phase suppresses the ability of late-firing replication origins to initiate. The suppression of late origin firing is dependent on the checkpoint kinases Mec1 and Rad53 (Santocanale & Diffley, 1998; Shirahige et al., 1998). A similar intra-S phase checkpoint is probably active in mammalian cells (Dimitrova & Gilbert, 2000; Feijoo et al., 2001). In mammalian cells, Rb is required for both G1/S and intra-S arrest in response to genotoxic stress (Chew et al., 1998; Harrington et al., 1998; Knudsen et al., 1998; Knudsen et al., 2000; Saudan et al., 2000). Activation of this Rb-dependent checkpoint is associated with a down-regulation of cyclin A (Knudsen et al., 1998; Guo et al., 2000; Knudsen et al., 2000; Sever-Chroneos et al., 2001). The response of U2OS and H1299 cells to geminin expression suggests that this intra-S checkpoint has been activated. Both cell lines arrest in S phase with high cyclin E level but low cyclin A. Further, p53 becomes phosphorylated on serine 15, indicative of the ATM/ATR checkpoints being activated (Abraham, 2001). Whether the use of the adenovirus delivery system augments the p53 activation is, however, unknown. Since Saos2 and BT549 (a breast cancer-derived cell line) both lack Rb, they would not be expected to undergo this early S phase arrest.
What might cause checkpoint activation when geminin is over-expressed in these cancer cell lines? One possibility is that it is a direct consequence of reducing the number of active replication origins. Replication forks probably stall quite frequently during the course of undisturbed S phases, but is not normally a problem since the other replication fork initiated from the adjacent replication origin can continue replication right up to the stalled fork. However, by reducing the number of active replication origins (and thus increasing the distance between adjacent origins), geminin might increase the probability of both adjacent replication forks stalling. The intervening DNA cannot now be replicated, so the replication forks do not disassemble and a persistent checkpoint signal is generated. The presence of stalled replication forks would account for the chromatin-bound PCNA seen in geminin-expressing U2OS cells. An alternative explanation for checkpoint activation in geminin-expressing cells is that the ~10 copies of Mcm2-7 loaded onto replication origins are all required for error-free DNA replication (Woodward et al., 2002). For example, if Mcm2-7 provide the replicative helicase responsible for unwinding the DNA ahead of the replication fork (Labib & Diffley, 2001), it is plausible that reducing their number might make it harder for the fork to progress or resume replication once difficulties arise.
The response of IMR90 primary fibroblasts to geminin overexpression appears quite different from that of the cancer cell lines. Although geminin blocked cell proliferation and reduced the levels of Mcm2 levels on chromatin, there was no sign of these cells entering S phase. Flow cytometry showed a sharp G1 peak whilst immunofluorescence showed little PCNA was associated with the chromatin. Both cyclin E and cyclin A were low in the geminin expressing cells, and p53 was not phosphorylated on serine 15. These results suggest that primary cells expressing geminin arrest before entry into S phase. Cip1/Waf1 levels were elevated and Rb remained unphosphorylated, which could potentially mediate the G1 arrest. In contrast to the established cell lines, however, there is no simple explanation for the trigger that brings about this arrest. It is unlikely that it is triggered by DNA damage, since there is no reason to think that geminin will damage DNA if replication forks are not initiated. Another possibility is that geminin itself directly blocks entry into S phase. However, this also seems unlikely because geminin is normally expressed in unperturbed S phases (McGarry & Kirschner, 1998; Wohlschlegel et al., 2000; Nishitani et al., 2001). The most likely explanation at present is that primary cells can respond directly to the absence of licensed replication origins by blocking entry into S phase - a “licensing checkpoint”. Monitoring whether origins are correctly licensed before permitting entry into S phase makes sense functionally since it would cause arrest at a stage where the problem could be rectified. When cells withdraw into G0, their replication origins become unlicensed, and we have suggested that this can provide a functional definition of the G0 state (Blow & Hodgson, 2002). The ability to judge whether origins have become re-licensed may be important for successfully re-entering the cell cycle from the G0 state. AdGFP-geminin infected primary cells may therefore be behaving like cells early in the process of G0 exit.
The Replication Licensing system as anti-cancer target
The results shown here suggest that geminin, or compounds mimicking its activity, would have the ability to specifically kill cancer cells. The replication licensing system is regulated in such a way as to prevent re-replication of DNA in a single cell cycle (Blow & Laskey, 1988; Diffley, 2001; Lei & Tye, 2001; Blow & Hodgson, 2002). It is activated in late mitosis and is turned off again in late G1 to ensure that replicated origins do not become re-licensed during S phase. The inactivation of licensing in S, G2 and M phases appears to be due to the high CDK levels present at these cell cycle stages, mediated at least in part by induction of geminin (McGarry & Kirschner, 1998; Wohlschlegel et al., 2000; Tada et al., 2001; Hodgson et al., 2002; Blow & Hodgson, 2002). Therefore once cells have entered S phase with an insufficient number of licensed origins to complete replication, they will never be able to license the inactive origins. Thus we imagine that once cells such as U2OS and H1299 had arrested in S phase following geminin overexpression, subsequent removal of the geminin would not save them from death. In contrast, primary cells arresting in G1 with an insufficient number of licensed origins remain in a cell cycle state where they should still be able to license new origins. Thus we imagine that after primary cells had arrested in G1 by geminin overexpression, subsequent removal of the geminin would allow them to finish licensing their origins before progressing into a normal S phase.
Unfortunately, there is no simply way of testing this novel idea at present, as adenovirus infection cannot easily be reversed. The only reported licensing inhibitor is geminin. The minimal region of geminin that contains inhibitory activity is ~90 amino acids, with a molecular weight of ~10 kDa (McGarry & Kirschner, 1998). Given the difficulty in delivering a molecule of this size into cells, we believe that for this potential to be realised, a cell-permeant small molecule that inhibits replication licensing is required. To this end, we have recently embarked on a screen for small molecule inhibitors of the replication licensing system that will allow us to test these ideas in more rigorous detail.
Materials and methods
Cell lines and culture conditions
The human osteosarcoma cell lines U2OS, Saos2, lung carcinoma H1299, breast carcinoma BT 549 and primary fibroblast IMR-90 were obtained from the American type culture collection. These cells were cultured in Dulbecco’s modified Eagle’s medium supplemented with 10% heat inactivated foetal calf serum and 0.5% gentamycin at 37°c in 5% CO2.
Adenoviral vectors and infection
Xenopus laevis geminin H lacking the destruction box sequence (RRTLKVIQP) was cloned into the pAdTrack-CMV vector. Xenopus geminin was used in this study because its function is well understood and it is closely homologous to the human gene. Replication defective recombinant adenoviruses expressing either GFP as control (Ad5GFP) or GFP and geminin (Ad5GFP-geminin) were generated as previously reported (He et al., 1998). For infections, appropriate numbers of cells were plated and the following day the media was removed and cells were infected by diluting the virus at the multiplicity of infection of 100 in a minimal amount of DMEM just to cover the cells. Mock infection was performed by treatment of cells with vehicle (media) only. One hour after incubation at 37°c, fresh medium was added. Cells were harvested at specific time points for analysis.
Western blot analysis
Cells were treated by mock infection or infection with Ad5GFP or Ad5GFP-geminin at the MOI of 100. Cells were harvested at selected time points and lysed in RIPA lysis buffer (50mM Tris-HCl, 150mM NaCl, 1%NP40, 0.5% sodium deoxycholate, 0.1%SDS, 1mM EDTA, 1mM PMSF, 1mM Na3VO4, 1mM NaF and 1μg/ml each of aprotinin, pepstatin and leupeptin) for 15 minutes on ice. Cell lysates were centrifuged and protein concentration was determined by Bio-Rad protein assay kit (Bio-Rad laboratories GmbH, Munchen). Equal amounts of cellular protein were electrophoresed in SDS-polyacrylamide gels and transferred to a Hybond-PVDF membrane (Amersham corp., Arlington Heights, IL). The membrane was first blocked with 5% non-fat dried milk and then incubated with the following primary antibodies: rabbit anti-Xenopus geminin (Tada et al., 2001), mouse anti-human BM28, rabbit anti-human cyclin A (transduction laboratories, Lexington, KY), mouse anti-human cyclin E (PharMingen, San Diego, CA), mouse anti-human p53 (Midgley et al., 2000) rabbit anti-human phospho p53-ser 15 (Cell signalling technology, Beverly, MA), rabbit anti-human p21 (C-19), rabbit anti-human PARP (H250) (Santa Cruz Biotechnology, Santa Cruz, CA), mouse anti-human actin (Oncogene Research Products, Boston, MA); and then with peroxidase-linked anti-mouse immunoglobulin or anti-rabbit immunoglobulin antibody (Sigma Corp.) Enhanced chemiluminescence reagents were used to detect the signals according to the manufacturer’s instruction (Pierce, Rockford, IL).
For BM28 immunoblotting, cells were treated prior to lysis as described (Todorov et al., 1995). Briefly, cells were washed with PBS and with cytoskeleton (CSK) buffer (10mM Pipes, pH7.0, 100mM NaCl, 300mM sucrose, 3mM MgCl2). Then the cells were extracted twice with CSK buffer containing 0.5% Triton X-100, 0.5 mM PMSF, 10 μg/ml of each of leupeptin, pepstatin and aprotinin for 5 min at 20°c. The supernatant corresponding to the non-chromatin bound fraction was separated by centrifugation at 1500 rpm for 5 min. The remaining pellet containing the chromatin bound fraction was lysed in RIPA lysis buffer as above.
Cell proliferation assay
Cell proliferation was assessed at 24, 48, 72 and 96 h after infection by measuring the conversion of tetrazolium salt, MTT to formazan according to manufacturer’s instruction (Promega Corp., Madison, WI). Briefly cells were plated into 96 well plates and infected with the adenoviral vectors 24 h later. At each time point 15μl of dye solution was added to each well and cultured at 37°c for 4 h. The reaction was stopped by the addition of 100μl of stop solution for 1 h. The absorbance was read at 570nm using a 96 well plate reader (Dynex technologies). The results were expressed as the percentage of the absorbance of control (uninfected) cells.
Cell cycle analysis
Both adherent and non-adherent cells were harvested, washed once with PBS and fixed in ice-cold 70% ethanol with vigorous mixing. Cells were pelleted, washed once with PBS and resuspended in 1ml of PBS at 5×105 cells/ml containing 25μg/ml propidium iodide and 0.1mg/ml RNase for 30 min in the dark at 30-37°c. Flow cytometric analysis was performed on a FACScan Flow cytometer (Beckton Dickinson, San Jose, CA). The data from 10,000 cells was collected for analysis. The sub-diploid population was calculated as an estimate of the apoptotic cell population.
Immunofluorescence analysis
72 or 96 h following adenoviral infection indirect immunofluorescence of chromatin bound PCNA (PC-10, Mouse anti-human) was done as described (Miura & Sasaki, 1999). For 5-bromo-2′-deoxyuridine (BrdU) staining, infected cells growing on a 2-well chamber slide (Nunc, Naperville, IL) were pulsed with 10μM BrdU for 30 min at 37°c followed by formaldehyde fixation, permeabilisation with 1% NP40 and acid denaturation of DNA. Cells were then stained with anti-BrdU antibody (Becton Dickinson, Ontario) followed by Texas-red labelled donkey anti-mouse secondary antibody (Sigma corp.,). TdT-mediated dUTP-x nick end labelling (TUNEL) assay to detect apoptotic cells was done using the In situ cell death detection kit, fluorescein (Roche diagnostics, East Sussex) according to the manufacturers protocol. Methanol fixation quenched GFP expression and did not interfere with fluorescein labelled secondary antibodies.
Transfections and colony formation assay
Transfections were done using the Effectene reagent (Qiagen) according to manufacturer’s protocol. For colony formation assays, 24 h post transfection with either empty pcDNA3, pcDNA3 expressing the destruction box deleted geminin or a mutant form of geminin lacking the c-terminal 126 amino acid residues (geminin-ΔC126) or XCdt1, cells were selected with 1mg/ml G418 (Life technologies, GIBCO) over 3 weeks. Surviving cells were then stained with Giemsa (Life technologies, GIBCO).
Acknowledgements
We thank Neil Perkins, Pedro Jares, Pamela Robertson, Jean Christophe Bourdon and Marcus Achison for help at various stages of this project. This work is the subject of UK patent application 0209508.1. This work was supported by a British Commonwealth scholarship to SS and Cancer Research UK [CRC] grant SP2385/0101.
References
- Abraham RT. Genes Dev. 2001;15:2177–2196. doi: 10.1101/gad.914401. [DOI] [PubMed] [Google Scholar]
- Arentson E, Faloon P, Seo J, Moon E, Studts JM, Fremont DH, Choi K. Oncogene. 2002;21:1150–1158. doi: 10.1038/sj.onc.1205175. [DOI] [PubMed] [Google Scholar]
- Blow JJ, Hodgson B. Trends Cell Biol. 2002;12:72–78. doi: 10.1016/s0962-8924(01)02203-6. [DOI] [PMC free article] [PubMed] [Google Scholar]
- Blow JJ, Laskey RA. Nature. 1988;332:546–548. doi: 10.1038/332546a0. [DOI] [PubMed] [Google Scholar]
- Burkhart R, Schulte D, Hu D, Musahl C, Gohring F, Knippers R. Eur. J. Biochem. 1995;228:431–438. [PubMed] [Google Scholar]
- Chew YP, Ellis M, Wilkie S, Mittnacht S. Oncogene. 1998;17:2177–2186. doi: 10.1038/sj.onc.1202443. [DOI] [PubMed] [Google Scholar]
- Diffley JF, Cocker JH, Dowell SJ, Rowley A. Cell. 1994;78:303–316. doi: 10.1016/0092-8674(94)90299-2. [DOI] [PubMed] [Google Scholar]
- Diffley JFX. Curr. Biol. 2001;11:R367–370. doi: 10.1016/s0960-9822(01)00196-8. [DOI] [PubMed] [Google Scholar]
- Dimitrova DS, Gilbert DM. Nature Cell Biol. 2000;2:686–694. doi: 10.1038/35036309. [DOI] [PMC free article] [PubMed] [Google Scholar]
- Donovan S, Harwood J, Drury LS, Diffley JF. Proc. Natl. Acad. Sci. U.S.A. 1997;94:5611–5616. doi: 10.1073/pnas.94.11.5611. [DOI] [PMC free article] [PubMed] [Google Scholar]
- Feijoo C, Hall-Jackson C, Wu R, Jenkins D, Leitch J, Gilbert DM, Smythe C. J. Cell Biol. 2001;154:913–923. doi: 10.1083/jcb.200104099. [DOI] [PMC free article] [PubMed] [Google Scholar]
- Gillespie PJ, Li A, Blow JJ. BioMed Central Biochem. 2001;2:15. doi: 10.1186/1471-2091-2-15. [DOI] [PMC free article] [PubMed] [Google Scholar]
- Guo N, Faller DV, Vaziri C. J. Biol. Chem. 2000;275:1715–1722. doi: 10.1074/jbc.275.3.1715. [DOI] [PubMed] [Google Scholar]
- Harrington EA, Bruce JL, Harlow E, Dyson N. Proc. Natl. Acad. Sci. U.S.A. 1998;95:11945–11950. doi: 10.1073/pnas.95.20.11945. [DOI] [PMC free article] [PubMed] [Google Scholar]
- He TC, Zhou S, da Costa LT, Yu J, Kinzler KW, Vogelstein B. Proc. Natl. Acad. Sci. U.S.A. 1998;95:2509–2514. doi: 10.1073/pnas.95.5.2509. [DOI] [PMC free article] [PubMed] [Google Scholar]
- Hodgson B, Li A, Tada S, Blow JJ. Curr. Biol. 2002;12:678–683. doi: 10.1016/s0960-9822(02)00778-9. [DOI] [PMC free article] [PubMed] [Google Scholar]
- Hua XH, Newport J. J. Cell Biol. 1998;140:271–281. doi: 10.1083/jcb.140.2.271. [DOI] [PMC free article] [PubMed] [Google Scholar]
- Knudsen ES, Buckmaster C, Chen TT, Feramisco JR, Wang JY. Genes Dev. 1998;12:2278–2292. doi: 10.1101/gad.12.15.2278. [DOI] [PMC free article] [PubMed] [Google Scholar]
- Knudsen KE, Booth D, Naderi S, Sever-Chroneos Z, Fribourg AF, Hunton IC, Feramisco JR, Wang JY, Knudsen ES. Mol. Cell. Biol. 2000;20:7751–7763. doi: 10.1128/mcb.20.20.7751-7763.2000. [DOI] [PMC free article] [PubMed] [Google Scholar]
- Labib K, Diffley JF. Curr. Opin. Genet. Dev. 2001;11:64–70. doi: 10.1016/s0959-437x(00)00158-1. [DOI] [PubMed] [Google Scholar]
- Labib K, Kearsey SE, Diffley JF. Mol. Biol. Cell. 2001;12:3658–3667. doi: 10.1091/mbc.12.11.3658. [DOI] [PMC free article] [PubMed] [Google Scholar]
- Lei M, Kawasaki Y, Tye BK. Mol. Cell. Biol. 1996;16:5081–5090. doi: 10.1128/mcb.16.9.5081. [DOI] [PMC free article] [PubMed] [Google Scholar]
- Lei M, Tye BK. J. Cell Sci. 2001;114:1447–1454. doi: 10.1242/jcs.114.8.1447. [DOI] [PubMed] [Google Scholar]
- Mahbubani HM, Chong JP, Chevalier S, Thömmes P, Blow JJ. J. Cell Biol. 1997;136:125–135. doi: 10.1083/jcb.136.1.125. [DOI] [PMC free article] [PubMed] [Google Scholar]
- Maine GT, Sinha P, Tye BK. Genetics. 1984;106:365–385. doi: 10.1093/genetics/106.3.365. [DOI] [PMC free article] [PubMed] [Google Scholar]
- Maiorano D, Moreau J, Mechali M. Nature. 2000;404:622–625. doi: 10.1038/35007104. [DOI] [PubMed] [Google Scholar]
- McGarry TJ, Kirschner MW. Cell. 1998;93:1043–1053. doi: 10.1016/s0092-8674(00)81209-x. [DOI] [PubMed] [Google Scholar]
- Midgley CA, Desterro JM, Saville MK, Howard S, Sparks A, Hay RT, Lane DP. Oncogene. 2000;19:2312–2323. doi: 10.1038/sj.onc.1203593. [DOI] [PubMed] [Google Scholar]
- Miura M, Sasaki T. Methods Mol. Biol. 1999;113:577–582. doi: 10.1385/1-59259-675-4:577. [DOI] [PubMed] [Google Scholar]
- Musahl C, Holthoff HP, Lesch R, Knippers R. Exp. Cell Res. 1998;241:260–264. doi: 10.1006/excr.1998.4041. [DOI] [PubMed] [Google Scholar]
- Nishitani H, Taraviras S, Lygerou Z, Nishimoto T. J. Biol. Chem. 2001;276:44905–44911. doi: 10.1074/jbc.M105406200. [DOI] [PubMed] [Google Scholar]
- Quinn LM, Herr A, McGarry TJ, Richardson H. Genes Dev. 2001;15:2741–2754. doi: 10.1101/gad.916201. [DOI] [PMC free article] [PubMed] [Google Scholar]
- Rowles A, Tada S, Blow JJ. J. Cell Sci. 1999;112:2011–2018. doi: 10.1242/jcs.112.12.2011. [DOI] [PMC free article] [PubMed] [Google Scholar]
- Santocanale C, Diffley JFX. Nature. 1998;395:615–618. doi: 10.1038/27001. [DOI] [PubMed] [Google Scholar]
- Saudan P, Vlach J, Beard P. EMBO J. 2000;19:4351–4361. doi: 10.1093/emboj/19.16.4351. [DOI] [PMC free article] [PubMed] [Google Scholar]
- Sever-Chroneos Z, Angus SP, Fribourg AF, Wan H, Todorov I, Knudsen KE, Knudsen ES. Mol. Cell. Biol. 2001;21:4032–4045. doi: 10.1128/MCB.21.12.4032-4045.2001. [DOI] [PMC free article] [PubMed] [Google Scholar]
- Shirahige K, Hori Y, Shiraishi K, Yamashita M, Takahashi K, Obuse C, Tsurimoto T, Yoshikawa H. Nature. 1998;395:618–621. doi: 10.1038/27007. [DOI] [PubMed] [Google Scholar]
- Stoeber K, Mills AD, Kubota Y, Krude T, Romanowski P, Marheineke K, Laskey RA, Williams GH. EMBO J. 1998;17:7219–7229. doi: 10.1093/emboj/17.24.7219. [DOI] [PMC free article] [PubMed] [Google Scholar]
- Stoeber K, Tisty TD, Happerfield L, Thomas GA, Romanov S, Bobrow L, Williams ED, Williams GH. J. Cell Sci. 2001;114:2027–2041. doi: 10.1242/jcs.114.11.2027. [DOI] [PubMed] [Google Scholar]
- Sun W, Hola M, Pedley K, Tada S, Blow JJ, Todorov IT, Kearsey SE, Brooks RF. J. Cell Sci. 2000;113:683–695. doi: 10.1242/jcs.113.4.683. [DOI] [PubMed] [Google Scholar]
- Tada S, Li A, Maiorano D, Méchali M, Blow JJ. Nature Cell Biol. 2001;2:107–113. doi: 10.1038/35055000. [DOI] [PMC free article] [PubMed] [Google Scholar]
- Tan D-F, Huberman JA, Hyland A, Loewen GM, Brooks JSJ, Beck AF, Todorov IT, Bepler G. BioMed Central Cancer. 2001;1:6. doi: 10.1186/1471-2407-1-6. [DOI] [PMC free article] [PubMed] [Google Scholar]
- Todorov IT, Attaran A, Kearsey SE. J. Cell Biol. 1995;129:1433–1445. doi: 10.1083/jcb.129.6.1433. [DOI] [PMC free article] [PubMed] [Google Scholar]
- Tsuruga H, Yabuta N, Hashizume K, Ikeda M, Endo Y, Nojima H. Biochem. Biophys. Res. Commun. 1997;236:118–125. doi: 10.1006/bbrc.1997.6865. [DOI] [PubMed] [Google Scholar]
- Wohlschlegel JA, Dwyer BT, Dhar SK, Cvetic C, Walter JC, Dutta A. Science. 2000;290:2309–2312. doi: 10.1126/science.290.5500.2309. [DOI] [PubMed] [Google Scholar]
- Wohlschlegel JA, Kutok JL, Weng AP, Dutta A. Am. J. Pathol. 2002 doi: 10.1016/S0002-9440(10)64178-8. in press. [DOI] [PMC free article] [PubMed] [Google Scholar]
- Woodward A, Li A, Blow JJ. Chemtracts. 2002 in press. [Google Scholar]